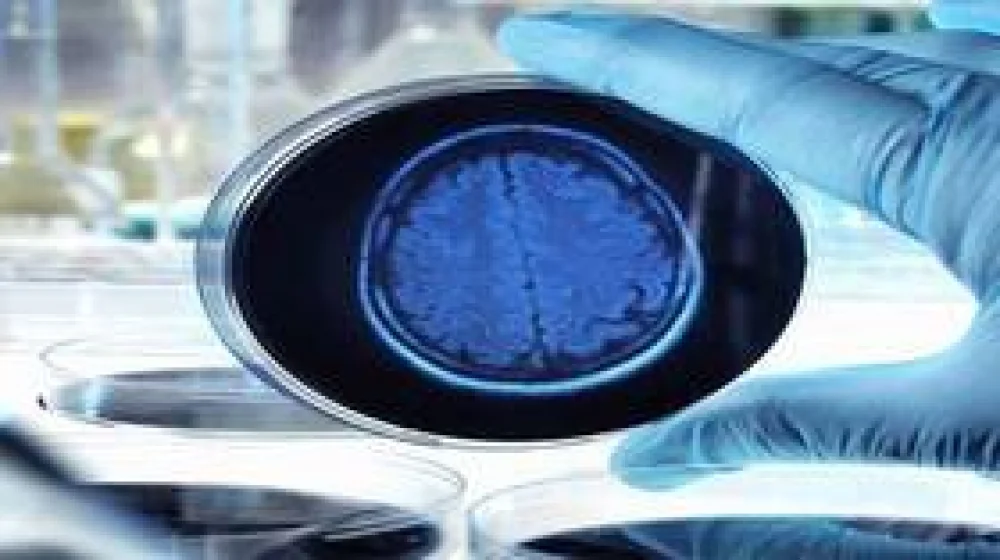

أخبارنا المغربية
في خطوة غير مسبوقة، نجح العلماء في زراعة أدمغة بشرية صغيرة في الفضاء لأول مرة، بهدف اختبار علاجات جديدة لأمراض مثل الزهايمر وباركنسون وإصابات الحبل الشوكي.
تمت هذه التجربة على متن محطة الفضاء الدولية (ISS)، حيث مكنت البيئة ذات الجاذبية المنخفضة الباحثين من زراعة الأدمغة الاصطناعية في 72 ساعة فقط، بينما كان هذا يستغرق أشهرًا على سطح الأرض.
الأدمغة الاصطناعية هي كتل خلوية تنمو في المختبر وتقلد بنية ووظائف الأعضاء البشرية، وقد سمحت للباحثين باختبار طريقة جديدة لعلاج الأمراض العصبية المستعصية.
العلاج الجديد، الذي طورته شركة "أكسونيس ثيرابيوتيكس" للتكنولوجيا الحيوية، يعتمد على فيروس معدّل ينقل العلاج الجيني إلى خلايا الجهاز العصبي المركزي (CNS)، وهو ما قد يكون مفيدًا بشكل خاص في علاج الزهايمر وباركنسون وإصابات الحبل الشوكي.
تشير الدراسات إلى أن حوالي 600,000 شخص في الولايات المتحدة يتم تشخيصهم سنويًا بإحدى هذه الأمراض، وأن نحو 18,000 حالة إصابة جديدة في الحبل الشوكي تحدث سنويًا.
تم اختبار العلاج بنجاح على الفئران، لكن الجينات التي تعالج الحيوانات غالبًا ما تفشل مع البشر، مما دفع الباحثين لاستخدام نماذج حية للأدمغة البشرية.
بينما يمكن للعلماء زراعة خلايا الجهاز العصبي المركزي على الأرض، فإن الجاذبية تؤثر في ترتيبها، مما يصعب زراعة نماذج ثلاثية الأبعاد دقيقة.
أما في الفضاء، فقد نجحت الأدمغة الاصطناعية في التشكّل بسرعة، مما سمح للباحثين بفحص فعالية العلاج الجديد بدقة.
وأشار شين هيغارتي، المؤسس المشارك والرئيس العلمي لشركة "أكسونيس ثيرابيوتيكس": "البحث في الفضاء لا يبدو كأمر متوقع، لكن استغلال ظروف الجاذبية الصغرى يمكن أن يفتح إمكانيات علمية غير مسبوقة".
في أغسطس 2023، تم إرسال عينات من الفيروسات المعدلة والخلايا العصبية الناضجة إلى محطة الفضاء الدولية في مهمة إعادة إمداد، حيث تم حقنها في جهاز "BioCell" المتخصص في زراعة الخلايا.
في غضون 72 ساعة فقط، تشكلت الأدمغة الاصطناعية ثلاثية الأبعاد وبدأت في التوهج، مما أثار حماسة الفريق البحثي.
"كان اليوم الحاسم عندما رأينا الأنسجة الكبيرة المتوهجة باللون الأخضر في المجهر"، حسبما قالت شيلا نيلسن من "بيوسيرف سبيس تكنولوجيز".
هذا الاكتشاف يُعدّ نقطة تحول رئيسية، حيث أظهر قدرة الفيروس المعدل على توصيل العلاج الجيني إلى الخلايا العصبية البشرية.